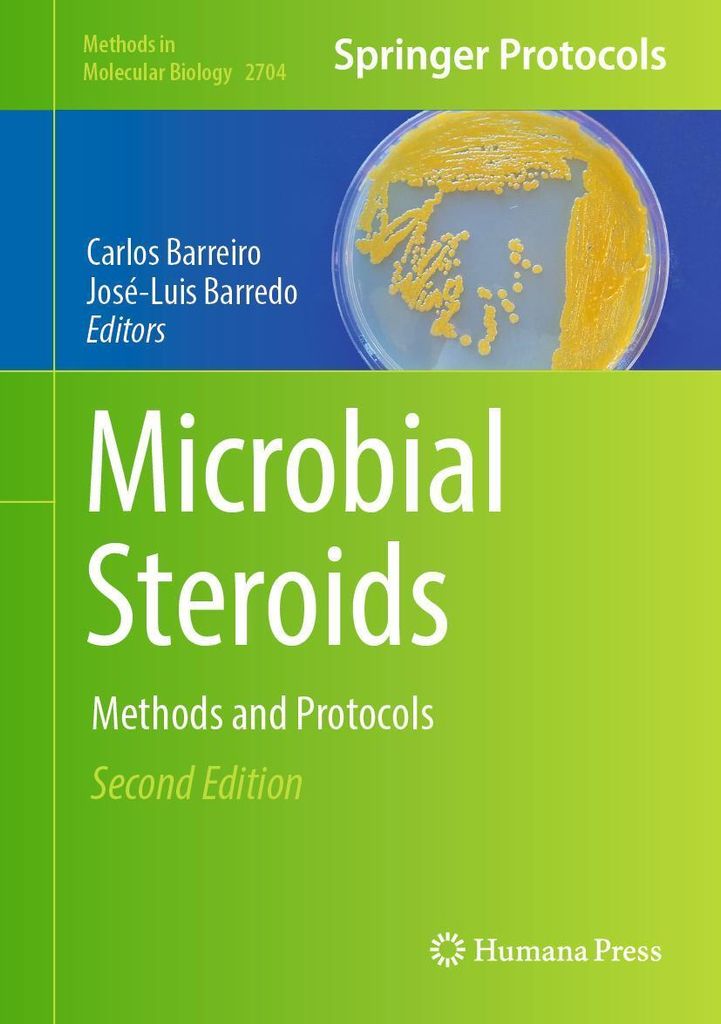
Microbial Steroids

3-teiliger Raumteiler mit Metallrahmen in Schwarz, Sichtschutz Raumtrenner
€57.99
inkl. MwSt. zzgl. Versand
Versand: €0.00

Tasse "MILAN ITALY STREET MAP ART" artboxONE - Städte,Reise,Städte / Mailand,Kartografie
€19.99
inkl. MwSt. zzgl. Versand
Versand: €4.99

Velours Kinderteppich Joy Kids Pink Rund, Größe:240 cm Rund
€229.90
inkl. MwSt. zzgl. Versand
Versand: €0.00

Auto Aufkleber Witten Herz Herzschlag 19x6 cm Schwarz Glanz Sticker Heckscheibenaufkleber
€8.99
inkl. MwSt. zzgl. Versand
Versand: €0.00

Unterrichtsraum Schild mit Text Richtungspfeil links Schule Schulung waagerecht A2 (420x594mm)
€54.99
inkl. MwSt. zzgl. Versand
Versand: €0.00

Facharztprüfung Allgemeinchirurgie, Viszeralchirurgie, Set von , Thieme, 978-3-13-244405-8
€130.00
inkl. MwSt. zzgl. Versand
Versand: €0.00

CONVERSE Sportcipő 'Chuck Taylor All Star Malden' Fiúk fekete , Méret 27
HUF 20,490.00
inkl. MwSt. zzgl. Versand

Galerie-Print "Ballettschuhe" 75x50 cm artboxONE
€199.99
inkl. MwSt. zzgl. Versand
Versand: €4.99

3 Fox Rage Jigköpfe Standup Lipstick Jigs Jighaken, Größe:25g / Gr. 4/0
€4.99
inkl. MwSt. zzgl. Versand
Versand: €4.99

Next Hose Jungen Größe 152 schwarz
€20.00
inkl. MwSt. zzgl. Versand
Versand: €4.90

Massivholzbett Honigbraun Kiefer 160x200 cm
€159.39
inkl. MwSt. zzgl. Versand
Versand: €0.00

Moravia Mauer-/Deckenpfosten 800 mm für Verkehrsspiegel der Größen 1 und 2
€91.99
inkl. MwSt. zzgl. Versand
Versand: €5.95

Česká biozahrada (Hradil Radomil)
€45.09
inkl. MwSt. zzgl. Versand
Versand: €0.00

Blut im Wasser, Taschenbuch von Herbert Vore, BoD – Books on Demand, 9783695192267
€19.99
inkl. MwSt. zzgl. Versand
Versand: €0.00

HENGST FILTER E1945LI Filter Innenraumluft
€22.98
inkl. MwSt. zzgl. Versand
Versand: €0.00

KLOKKERHOLM 3515878 Spritzblech, Bremsscheibe OE 2034230420 kompatibel mit SLK, CLK, CLC-Klasse, C-Klasse
€22.00
inkl. MwSt. zzgl. Versand
Versand: €10.00

Mein superstarker Schulanfangsblock. Logisch denken und kombinieren
€6.50
inkl. MwSt. zzgl. Versand
Versand: €3.95

KitchenYeah Herdabdeckplatte Schäumendes Meer bei Sonnenaufgang , 85x52cm, Küche Deko, Glaskeramikkochfeld Herdabdeckung, Abdeckplatte fùr Koc...
€28.95
inkl. MwSt. zzgl. Versand
Versand: €0.00

Arbeitshandschuhe Vollleder - Größe: 8
€2.99
inkl. MwSt. zzgl. Versand

Leuchtbild Acrylglas ️ Porträt eines Löwen | Canvalight DIA Quadrat 120 x 120 / kaltweiß
€739.00
inkl. MwSt. zzgl. Versand

IZIA Ruha Női zöld , Méret M
HUF 76,670.00
inkl. MwSt. zzgl. Versand

Ubiquiti Antenne PBE-5AC-500 Airmax PowerBeam AC 5GHz 500mm
€209.90
inkl. MwSt. zzgl. Versand
Versand: €0.00

400 Tüten Flachbeutel PE Beutel mit 50mμ 100 x 200
€14.86
inkl. MwSt. zzgl. Versand
Versand: €3.90

Döhnert Aluminium Bilderrahmen Alaska 30x60 cm Silber matt
€55.35
inkl. MwSt. zzgl. Versand

Bodenplatte für F90 Leichtbauschornstein - eka L90 Compact
€37.47
inkl. MwSt. zzgl. Versand
Versand: €8.90

Das Mitarbeitergespräch - Ein vielschichtiges Führungsinstrument
€74.00
inkl. MwSt. zzgl. Versand
Versand: €0.00

Dämpfer, Fahrerhauslagerung MONROE CB0061
€167.43
inkl. MwSt. zzgl. Versand
Versand: €15.00

Kiwistar - T-Shirt - Graumeliert - Bosnien Herzegowina BIH Motiv Bedruckt Funshirt Design Print - mit Motiv Bedruckt - Funshirt Design - Sport - Fr...
€16.99
inkl. MwSt. zzgl. Versand
Versand: €1.00

Leinwandbild ️ Romantische Blumenillustration | Hochformat | wandbild.com 150 x 300 / Stärke 4 cm
€1,099.00
inkl. MwSt. zzgl. Versand

Whitney Houston - "Moment Of Truth Tour" Kapuzenpullover für Kinder, Zum Überziehen TV25051 (116) (Schwarz)
€46.24
inkl. MwSt. zzgl. Versand
Versand: €2.70

Kaufverhalten und Kaufprozess von Dienstleistungen im B2B-Bereich. Was sind die Unterschiede zum Einkauf materieller Güter?
€47.95
inkl. MwSt. zzgl. Versand
Versand: €0.00

AISIN QZ-056 Kupplungsgeberzylinder für FORD Fiesta Mk5 Schrägheck (JH1, JD1, JH3, JD3) FUSION (JU) Fiesta Mk5 Kastenwagen für MAZDA 2 (DY)
€32.86
inkl. MwSt. zzgl. Versand
Versand: €0.00

Holzbild "Frida Love Dog" artboxONE - Floral,Tiere,Menschen
€39.99
inkl. MwSt. zzgl. Versand

PFIFF Vollbesatzhose ́Maike ́, Farbe:blau, Groesse:176
€78.72
inkl. MwSt. zzgl. Versand
Versand: €6.95

Vollbart Farmer – 6 Farben Farbe: braun
€41.35
inkl. MwSt. zzgl. Versand
Versand: €4.95

Villeroy & Boch Collaro Waschtischunterschrank 1000 x 548 x 500mm, mit LED Beleuchtung
€2,537.08
inkl. MwSt. zzgl. Versand
Versand: €85.00

MEPAL Vorratsdosenset 3-teilig Omnia
€24.99
inkl. MwSt. zzgl. Versand
Versand: €5.99

Vorel worki na opony 30μm - 8szt.
€6.13
inkl. MwSt. zzgl. Versand
Versand: €9.95
Home Fashion, Tree and Snowflakes gold, Cocktail-Servietten aufgefaltetes Maß 25 cm x 25 cm, im Viertelfalz, 20 Stück pro Pack, 12 Pack pro Karton
€23.81(€1,984.17 / ct)
inkl. MwSt. zzgl. Versand
Versand: €6.99

M2000 Schlüsselanhänger personalisiert mit LKW u.Kennzeichen!
€21.95
inkl. MwSt. zzgl. Versand
Versand: €2.25

Herren Grafik T-Shirt Direkt aus Palembang – Straight Outta Palembang – Öko-Verantwortlich Vintage Jahrgang Kurzarm Lustige Druck Geburtstag G...
€26.95
inkl. MwSt. zzgl. Versand
Versand: €4.95

DAIWA PROREX SLIM SHADY, Gummifisch, 13,5cm, Golden Shiner, 15100-301
€82.30
inkl. MwSt. zzgl. Versand
Versand: €7.60

Ergonomischer Komfortschaum Topper | 100 x 200 | für alle Matratzen | XDREAM Pure Matratzenauflage
€43.90
inkl. MwSt. zzgl. Versand
Versand: €0.00

Blend BHFibi Herren Pullover Sweater Baumwollmischung regular fit
€34.95
inkl. MwSt. zzgl. Versand
Versand: €0.00

Leuchtbild Acrylglas ️ Nebel und Regenbogen zwischen den Bergen | Canvalight DIA Hochformat 60 x 80 / warmweiß bis kaltweiß
€689.00
inkl. MwSt. zzgl. Versand

Eat Joy
€28.17
inkl. MwSt. zzgl. Versand
Versand: €0.00

MINOTI Leggings Lányok fekete , Méret 110-116
HUF 13,190.00
inkl. MwSt. zzgl. Versand

CASAMODA Herren Businesshemd Kurzarm Kent Comfort-Fit Rot 43
€69.96
inkl. MwSt. zzgl. Versand
Versand: €0.00

1 Paar Ohrstecker, galvanisch, Kunstperlen, Zirkonia, Temperament, dekorative Dekoration, Nische, funkelnde geteilte Creolen, Schmuckzubehör
€3.63
inkl. MwSt. zzgl. Versand
Versand: €4.99

Das Komplott - John Grisham, Audio, 9783837121391
€13.95
inkl. MwSt. zzgl. Versand
Versand: €0.00

MuchoWow Mülltonnenaufkleber Gold - Farbe - Streifen - Luxus - Abstrakt 44x98 cm - Containeraufkleber - Aufkleber - Mülltonnen-Aufkleber
€21.95
inkl. MwSt. zzgl. Versand
Versand: €0.00

Cindylove - "The Maurah" Bodysuit für Damen LW508 (Einheitsgröße) (Schwarz)
€7.49
inkl. MwSt. zzgl. Versand
Versand: €2.70

Wandbild Leinwandbild Hände Love Pop Art: 80x120x2cm
€199.00
inkl. MwSt. zzgl. Versand
Versand: €0.00

Harry Potter - Il Marchio Nero T-shirt grigia - L - Grigio
€24.95
inkl. MwSt. zzgl. Versand
Versand: €13.90

Windbreaker-Frontzip
€67.95
inkl. MwSt. zzgl. Versand
Versand: €0.00

6x UV-Liquid 9H Panzerglas für Samsung Galaxy S24 3D KLAR echtes Tempered Panzerhartglas Schutzglas Displayschutz Panzerfolie Schutzfolie Screen P...
€28.40
inkl. MwSt. zzgl. Versand
Versand: €0.00

Trollkids Winterboots "Finnmark" in Türkis - 47% | Größe 33 | Kinderstiefel
€79.95
inkl. MwSt. zzgl. Versand
Versand: €4.95

Plissee Klemmfix Faltstore UNIVERSAL Faltrollo ohne Bohren - 35 x 200 cm - grau
€44.16
inkl. MwSt. zzgl. Versand
Versand: €6.99

Poster Limited Edition: Stern Groß dunkelrot/weiß / 50 cm x 70 cm
€26.90
inkl. MwSt. zzgl. Versand

Tulup Kühlschrankdekoration - 70x190 cm - Aufkleber auf dem Kühlschrank - Landschaften Alpen
€49.99
inkl. MwSt. zzgl. Versand
Versand: €0.00

ADIDAS SPORTSWEAR Funkcionális felső 'Essentials' Női kék , Méret S
HUF 8,190.00
inkl. MwSt. zzgl. Versand

langhantel polster, extra dicke nackenpolster langhantel- Barbell Pad nackenschutz für hip thrust und squat,(Blau)
€12.54
inkl. MwSt. zzgl. Versand
Versand: €0.00

Palivovy filtr
€28.93
inkl. MwSt. zzgl. Versand
Versand: €7.10
Microbial Steroids
€207.14
inkl. MwSt. zzgl. Versand
Versand: €0.00

vhbw Auslöseknopf kompatibel mit Leica M8, M6, M9, M9-P, M3, M7, M-P, M-Monochrom, M2, M1, M-A, M-E Kamera - Ergonomischer Ersatzknopf, Metall, Rot
€6.99
inkl. MwSt. zzgl. Versand
Versand: €0.00

Die heutigen Auffassungen vom Neuprotestantismus
€109.95
inkl. MwSt. zzgl. Versand
Versand: €0.00

Uhlsport Bionikframe Baselayer Herren - Schwarz | Größe: XL
€58.62
inkl. MwSt. zzgl. Versand
Versand: €0.00

BOSCH Reparatursatz, Common-Rail-System F 00Z C99 970
€1.44
inkl. MwSt. zzgl. Versand
Lenovo ThinkPad T16 G4 16" WUXGA U5 225U 16GB/512GB Win11 Pro 21QE0035GE
€1,757.67
inkl. MwSt. zzgl. Versand
Versand: €6.99

Briefmarken Spanien 1997 Mi 3343,3346,3350-3351 (kompl.Ausg.) postfrisch Blaue Schleife
€1.99
inkl. MwSt. zzgl. Versand
Versand: €2.99

Mr. & Mrs. Panda Organic Baby Hoodie Einhorn König mit Schwert 12. - 18. Monat - Natural Raw - Geschenk, Ritter, Mittelalter, Unicorn, Kapuzenshir...
€38.49
inkl. MwSt. zzgl. Versand
Versand: €4.90

Alu-Dibond "London England Skyline PurpleGold" 30x20 cm artboxONE
€59.99
inkl. MwSt. zzgl. Versand

Hülle Für Samsung Galaxy A34 5G - Blau Schmetterling, Schmetterling, Feminine Designs
€9.16
inkl. MwSt. zzgl. Versand
Versand: €4.60

Puig 130NA 3.0 Brems-Kuppl.Satz verfügbar für KAWASAKI ZX-10R Ninja (Type ZXT02C) 2018--
€129.00
inkl. MwSt. zzgl. Versand
Versand: €6.90

APS Espresso-Obere, Höhe: 55 mm, ø: 60 mm taupe
€2.90
inkl. MwSt. zzgl. Versand
Versand: €4.95

Poster 30x20 cm "Pineapple 01" artboxONE - Natur,Essen & Trinken,Abstrakt,Schwarzweiß - Ananas,Frucht,Obst,Frucht,Topisch,Sommer,Skandinavisch
€14.99
inkl. MwSt. zzgl. Versand
Versand: €4.99

MuchoWow Wandteppich Wandbehang Schwan - Wasser - Tiere - Vogel 150x150 cm Tapisserie Dekoration Wandtuch - Wohnaccessoires - Modernes
€114.95
inkl. MwSt. zzgl. Versand
Versand: €0.00

love & roses Tréning póló Női rózsaszín , Méret 10
HUF 22,350.00
inkl. MwSt. zzgl. Versand

Buderus Logatrend Kompaktheizkörper, C-Plan.2, Typ 33, 600x400 (HxL)
€296.40
inkl. MwSt. zzgl. Versand
Versand: €0.00
Veloflex Sammelhülle, A4, PP, 9 Taschen
€86.00
inkl. MwSt. zzgl. Versand
Versand: €0.00

Herren Grafik T-Shirt Gitarre und Rock'n'Roll seit 2001 – Guitar and Rock & Roll Since 2001 – Geschenk 23. Geburtstag Jahrestag 23 Jahre Jubil...
€24.95
inkl. MwSt. zzgl. Versand
Versand: €4.95

Herren Grafik T-Shirt Ich weigere mich etwas anderes als einen Beitrag zu leisten – I Refuse To Be Anything But Contributive – Öko-Verantwortlich
€24.95
inkl. MwSt. zzgl. Versand
Versand: €4.95

1/2 Stück künstliche Bougainvillea Speetabilis zum Aufhängen im Kokospalmen-Blumenkorb, UV-beständig, künstliche Blume, Dekoration für drinne...
€41.20
inkl. MwSt. zzgl. Versand
Versand: €0.00

Recht / Right FAN Lüfter Kühler kompatibel für Acer Swift 3 SF314-56G-75M9 , SF314-56G-75SV
€32.99
inkl. MwSt. zzgl. Versand
Versand: €0.00

VIVANCE Hálóingek Női kék , Méret 36
HUF 6,690.00
inkl. MwSt. zzgl. Versand

Coloray Fototapete 290x290 cm Vlies-Fototapete - FigurenstädteFoto.
€154.99
inkl. MwSt. zzgl. Versand
Versand: €0.00

ALUFELGE DEZENT KF silver 7x18 5x108 ET 47.5 SILVER
€166.99
inkl. MwSt. zzgl. Versand
Versand: €0.00

Karlie RONDO Leine genietet - Natur, 100cm/12mm
€10.94
inkl. MwSt. zzgl. Versand
Versand: €4.30

Megaman LED-Lampe A60 E27 4000K MM21161
€8.79
inkl. MwSt. zzgl. Versand
Versand: €5.95

Poster ️ Hochlandrinder - Harmonie der Natur | Hochformat | BigBilder 100 x 200
€119.00
inkl. MwSt. zzgl. Versand

Bronze Age World Tour – Lingua: Inglese
€13.44
inkl. MwSt. zzgl. Versand
Versand: €2.90

Verstellbare Rohrzange 250 mm Cr-V 10"
€22.12
inkl. MwSt. zzgl. Versand
Versand: €0.00

Cool Club Ruha Lányok fehér , Méret 164
HUF 11,490.00
inkl. MwSt. zzgl. Versand

Canvalight Leuchtbild ️ Sandstrand und Düne | Hochformat | wandbild.com 120 x 160 / kaltweiß
€899.00
inkl. MwSt. zzgl. Versand

puma BVB BORUSSIA DORTMUND home jersey men's 25 / 26 - YAN COUTO 2 s
€119.85
inkl. MwSt. zzgl. Versand

WRANGLER, Herren Jeanshosen, Straight fit, GREENSBORO, W31 L34, Blau, Jeans, baggyjeans, buggy
€69.99
inkl. MwSt. zzgl. Versand
Versand: €0.00

Doppelrollo DuoRollo Klemmfix ohne Bohren Seitenzug Fenster Rollo hellgrau 70cm (66cm Stoffbreite) 210 cm
€20.49
inkl. MwSt. zzgl. Versand
Versand: €0.00

KIENZLE Digitaler Funkwecker Quadratisch
€19.57
inkl. MwSt. zzgl. Versand
Versand: €0.00

Briefmarken UNO - New York 2003 Mi 925-928 Kleinbogen (kompl.Ausg.) postfrisch Vögel
€19.99
inkl. MwSt. zzgl. Versand
Versand: €2.99

Kiwistar - T-Shirt tailliert - Damen - türkis - Dänemark - Dänisch Umriss - mit Motiv Bedruckt - Funshirt Design - Sport - Freizeit - Damen - S
€14.99
inkl. MwSt. zzgl. Versand
Versand: €1.00
